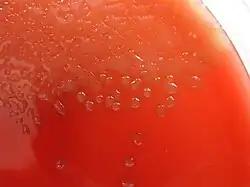

Agar sangre
El agar sangre es una combinación de un agar base (agar nutritivo) con el agregado de 5 % de sangre ovina,[1] también puede usarse sangre humana, para cultivos en una placa de Agar. El agar sangre aporta muchos factores de enriquecimiento. Se usa también para ver la capacidad hemolítica de los microorganismos patógenos (que es un factor de Virulencia). Observando los halos hemolíticos alrededor de las colonias se determina el tipo de hemólisis que posee:[2]
- alfa: halos verdosos (oxidación de la hemoglobina de los glóbulos rojos a metahemoglobina en el medio)
- beta: halos incoloros (hemolisis total)
- gamma: inexistencia de halos (sin hemolisis)
FUNDAMENTO:
Dada la excelente base nutritiva, permite el crecimiento de prácticamente todos los microorganismos que pudieran estar presentes. Si se añade sangre se pueden determinar las distintas formas de hemólisis que pudieran tener lugar. Si se calienta se obtiene el Agar Chocolate, también muy empleado. Por la adición de distintos antibióticos se obtienen medios con caracteres selectivos.
Fórmula (por litro):
Infusión de Corazón (a partir de 375 g)........................... 10,0 g
Peptona de Carne ...................................... 10,0 g
Sodio Cloruro ............................................. 5,0 g
Agar Agar............................................................ 15,0 g
pH final: 7,3 ±0,2
Preparación:
Suspender 40 g en 1 l de agua destilada; calentar y agitar hasta ebullición y hervir durante 1 minuto. Esterilizar a 121 °C durante 30 minutos (para cantidades de más de 1 litro). Homogeneizar y distribuir en tubos de ensayo y esterilizar a 121 °C durante 15 minutos. Para preparar placas de Agar Sangre incorporar 5 a 8% de Sangre desfibrinada antes de distribuir en placas. Para una mejor conservación de la placa de Agar Sangre y para obtener halos hemolíticos más claros ajustar el pH a 6,8 ±0,2. Si se utiliza como medio basal se obtendrán mejores crecimientos a pH 7,3 ±0,2.
Modo de empleo:
Sembrar las placas en la superficie del medio. Incubar a 37 °C de 24 a 48 horas.
Control de Calidad:
Control físico-químico:
Aspecto: polvo fino. Solubilidad: total. Color: tostado. pH: 7,3 ±0,2
Control microbiológico:
A partir de cepas patrón, después de incubación a temperatura de 37 °C y observados a las 24 horas. Placas preparadas con un 5% de sangre de carnero.
Neisseria meningitidis ATCC 13090 , Crecimiento : Bueno , Gama Hemolisis
Staphylococcus aureus ATCC 25923 , Crecimiento : Bueno , Beta Hemolisis
Beta Staphylococcus epidermidis ATCC 12228 , Crecimiento : Bueno , Gama Hemolisis
Streptococcus pneumoniae ATCC 6303, Crecimiento : Bueno , Alpha Hemolisis
Alfa Streptococcus pyogenes ATCC 19615 , Crecimiento : Bueno , Beta Hemolisis.
-
Hemolisis de Streptococcus:
izquierda: alfa hemolisis (hemolisis parcial) por S. mitis
centro: beta hemolisis (hemolisis total) por S. pyogenes
derecha: gamma hemolisis (sin hemolisis) por S. salivarius. -
Agar sangre para el diagnóstico de infecciones. A la izquierda positivo para infección por Staphylococcus, a la derecha positivo para un cultivo de Streptococcus -
Beta hemolisis en agar sangre, se observan tres colonias centrales y sus halos de hemolisis. -
Prueba de CAMP positiva.
Referencias
- ↑ Koneman, Elmer W.; Allen, Stephen (30 de junio de 2008). Koneman. Diagnostico Microbiologico/ Microbiological diagnosis: Texto Y Atlas En Color/ Text and Color Atlas. Ed. Médica Panamericana. ISBN 9789500608954. Consultado el 9 de noviembre de 2017.
- ↑ Mad, Editorial; Oliver, Antonio Caballero; Garcia, Luis Silva; Fuente, Nicolas Fernandez De La; Garcia, Carmen Silva; Bermejo, Ma Jose Garcia (24 de marzo de 2006). Técnico especialista en laboratorio de atención primaria del instituto catalán de la salud. Temario volumen ii. MAD-Eduforma. ISBN 9788466555388. Consultado el 9 de noviembre de 2017.